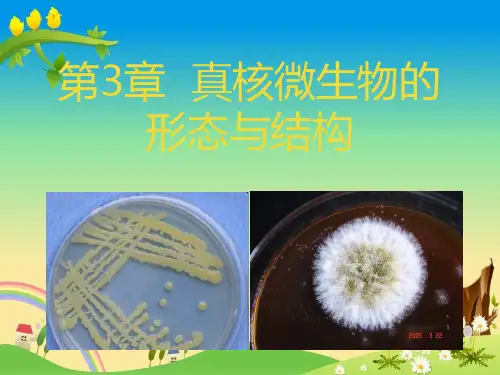

第三章 真核微生物
- 格式:ppt
- 大小:17.60 MB
- 文档页数:110









第三章真核微生物一、名词解释霉菌半知菌真核微生物有隔菌丝无隔菌丝酵母菌真菌的有性繁殖有性孢子无性孢子节孢子厚垣孢子分生孢子孢囊孢子游动孢子子囊孢子接合孢子无性繁殖无性孢子菌丝匍匐枝(匍匐菌丝) 假根孢子囊真菌菌丝体初生菌丝次生菌丝囊轴菌褶真菌子实体担孢子卵孢子赤霉素锁状联合半知菌闭囊壳子囊壳子囊盘子囊果担子果核配质配菌环菌索子座鞭毛菌配子蘑菇圈红色面包霉真菌生活史菌体二型性桶状分隔(复式隔)二、填空1.真核微生物具有的三种主要特征是、和,其主要类群有、和。
2.酵母菌细胞形态有、、、或等多种,其繁殖方式有(1) 和(2) ,其中(1)又有、和。
3.霉菌菌丝特化器官主要有、、、、和等。
4.霉菌的无性孢子有、、、和,有性孢子有、和,其有性繁殖过程为、和。
5.酵母菌的营养体既可以单倍体(n)也可以二倍体(2n)形式存在,酿酒酵母是这类生活史的代表,其特点为、和。
6 .真菌细胞的染色体除含有双螺旋脱氧核糖核酸以外,还含有和 .7 .原核细胞和真核细胞的三项主要区别在、、 .8 .真核微生物的电子传递链存在于和上,原核生物的电子传递链存在于上.9 .真菌在长期的自然选择下,其营养菌丝或菌丝体发生多种变态,以满足生长发育的需要.其菌丝变态有、和;菌丝体的变态有、和 .10 .真菌无性繁殖方式有、、和 .11 .酵母菌的无性繁殖方式主要有和 .12 .真菌的有性繁殖过程可以分为,和三个阶段.13 .真核微生物包括有、和等,它们的大小以单位来表示.14 .真核微生物的细胞壁特有的组分是 .酵母菌的细胞壁主要成分是和 .而大部分霉菌的细胞壁是由组成的.15 .NA由于含有,故带有很高的负电荷,在原核生物细胞中,负电荷被和中和;在真核生物中,则被所中和.16 .真菌的有性孢子的种类有:、、和四种;真菌的无性孢子的种类有、、、和五种.17 .真菌生长的最适PH一般是 .18 .Ainsworth(1973)真菌分类系统将真菌门分成亚门,亚门,亚门,亚门和亚门.19 .啤酒酵母菌在分类上属于亚门的真菌 .20 .典型担子菌的担子上着生有个担孢子.21 .典型的子囊菌的子囊中通常含有个孢子.22 .鞭毛菌亚门的真菌,无性繁殖产生孢子,有性生殖产生孢子.23 .真菌卵孢子是由两个大小不同的配子囊经结合后形成的,其中小型配子囊叫,大型配子囊叫 .24 .有一类真菌,由于仅发现,未发现,所以在真菌学中叫半知菌.25 .赤霉菌在分类学上属于亚门的真菌.26 .根霉的形态特征是具有和且菌丝;曲霉的形态特征是具和,菌丝;青霉的形态特征是具.27 .霉菌的繁殖方式有两种,即为和,而细菌则以为主要方式.28 .酵母菌的繁殖分为及繁殖两大类.能产生的酵母细胞必须是双倍体.29 .分生孢子梗状如扫帚是的重要分类特征.30 .蘑菇的生活史一般包括三个阶段、和.三、是非题1.酵母菌细胞和真菌细胞的细胞膜上都有甾醇成分。